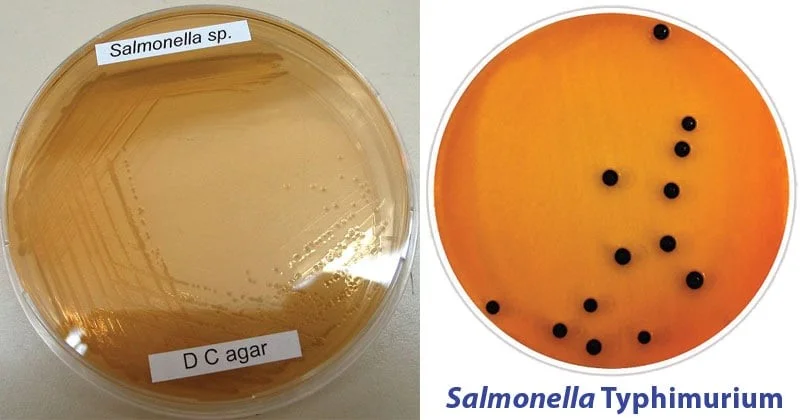
دئوکسی‌کولات سیترات آگار

مقدمهای بر محیط کشت DCA
- محیط کشت DCA (دئوکسیکولات سیترات آگار) با اصلاح فرمول محیط کشت Leifson به دست آمده و برای جداسازی گونههای سالمونلا (Salmonella) و شیگلا (Shigella) توصیه میشود.
- این محیط مشابه محیط کشت دئوکسیکولات آگار است، اما به دلیل افزایش غلظت نمکهای سیترات و دئوکسیکولات، برای پاتوژنهای رودهای نسبتاً انتخابیتر است.
- سدیم دئوکسیکولات در pH بین 7.3 تا 7.5، رشد باکتریهای گرم مثبت را مهار میکند. نمکهای سیترات با غلظت موجود در فرمولاسیون، رشد باکتریهای گرم مثبت و سایر ارگانیسمهای معمولی روده را مهار میکنند.
- بنابراین این محیط یک محیط انتخابی و افتراقی است که معمولاً برای ایزولاسیون پاتوژنهای رودهای استفاده میشود.
ترکیبات دئوکسیکولات سیترات آگار (محیط کشت DCA)
| عناصر | گرم در لیتر |
| HI solids | 10 |
| پروتئوز پپتون (Proteose peptone) | 10 |
| لاکتوز (Lactose) | 10 |
| سدیم دئوکسیکولات | 5 |
| نوترال رد (Neutral red) | 0.02 |
| سیترات سدیم (Sodium citrate) | 20 |
| سیترات آمونیوم فریک (Ferric ammonium citrate) | 2 |
| آگار | 13.5 |
pH نهایی (در دمای 25 درجه سانتیگراد): 0.2±7.5
اصول محیط کشت DCA
- HI solids منبع کربن و نیتروژن است و منجر به مهار باکتریهای کلیفرم (Coliform) میشود.
- پروتئوز پپتون کربن، نیتروژن، ویتامینها و مواد معدنی را فراهم میکند.
- باکتریهای کلیفرم و باکتریهای گرم مثبت به دلیل وجود سدیم دئوکسیکولات، سیترات سدیم و سیترات آمونیوم آهن، مهار یا تا حد زیادی سرکوب میشوند.
- دی پتاسیم فسفات محیط را بافر میکند.
- لاکتوز به افتراق باسیلهای روده کمک میکند، زیرا باسیلهای تخمیرکنندههای لاکتوز کلنیهای قرمز تولید میکنند در حالی که باسیلهای غیر تخمیرکننده لاکتوز کلنیهای بیرنگ تولید میکنند.
- باکتریهای کلیفرم در صورت وجود، کلونیهای صورتی رنگ را روی این محیط ایجاد میکنند.
- تجزیه لاکتوز باعث اسیدی شدن محیط اطراف کلنیهای مربوطه میشود و رنگ نشانگر PH نوترال رد به قرمز تغییر میکند. این کلنیها معمولاً به دلیل اسیدی شدن محیط، توسط یک ناحیه کدر از رسوب اسید دئوکسیکولیک (Deoxycholic acid) نیز احاطه شده اند.
- سدیم دئوکسیکولات با نوترال رد در یک محیط اسیدی ترکیب شده و باعث میشود که رنگ محلول پس از رسوب دئوکسی کولات از بین برود.
- کاهش سیترات آمونیوم آهن به سولفید آهن، با تشکیل سولفید آهن سیاه مشخص میشود.
- گونههای سالمونلا و شیگلا لاکتوز را تخمیر نمیکنند، اما سالمونلا ممکن است H2S تولید کرده و کلونیهای بیرنگ با یا بدون مراکز سیاه تشکیل دهد.
- ترکیب سیترات و آهن (Fe) اثر هیدرولیزی قوی بر روی آگار دارد که محیط را گرم کرده و یک آگار نرم و غیرکشسان تولید میکند.

آمادهسازی و روش استفاده از دئوکسیکولات سیترات آگار
- 52 گرم از آگار را در 1000 میلیلیتر آب مقطر بریزید.
- آن را حرارت داده تا به جوش آید و محیط کاملا حل شود.
توجه: اتوکلاو نکنید. از حرارت دادن بیش از حد خودداری کنید زیرا برای محیط مضر است.
- محیط را تا دمای 45 تا 50 درجه سانتیگراد خنک کنید. آن را خوب مخلوط کرده و در پلیتهای پتری استریل بریزید.
- قبل از استفاده سطح آگار را خشک کنید.
- محیط را با مدفوع یا سوابهای رکتوم (Rectal swab) به طور سنگین تلقیح کنید و بخشی از تلقیح اولیه را پخش کنید تا در قسمتهایی از پلیت، کلنیها به خوبی از هم جدا شده بدست آید.
- محیط را به مدت 18 تا 24 ساعت در دمای 35 درجه سانتیگراد انکوبه کنید.
- اگر ارگانیسمها رشد کندی دارند یا اگر ارگانیسم غیر تخمیرکننده لاکتوز مشاهده نشد، برای 24 ساعت دیگر محیط را انکوبه کنید.
تفسیر نتایج در محیط کشت DCA
ارگانیسمهای غیر تخمیرکننده لاکتوز، کلنیهای شفاف، بی رنگ تا صورتی روشن یا مایل به قهوهای با یا بدون مرکز سیاه ایجاد میکنند.
ارگانیسمهای تخمیر کننده لاکتوز یک کلنی قرمز با یا بدون رسوبی از صفرا ایجاد میکنند.
| ارگانیسم | رشد |
| اشریشیا کلی (Escherichia coli) | رشد ضعیف؛ صورتی رنگ با رسوب صفرا و عدم تولید H2S |
| سالمونلا انتریتیدیس (Salmonella Enteritidis) | رشد بسیار زیاد؛ بیرنگ؛ تولید H2S، کلنیهایی با مرکز سیاه |
| سالمونلا تیفیموریوم (Salmonella Typhimurium) | رشد بسیار زیاد؛ بیرنگ؛ تولید H2S، کلنیهایی با مرکز سیاه |
| شیگلا فلکسنر (Shigella flexneri) | رشد خوب؛ بیرنگ |
| سالمونلا آبونی (Salmonella Abony) | رشد بسیار زیاد؛ بیرنگ؛ تولید H2S، کلنیهایی با مرکز سیاه |
| شیگلا سونئی (Shigella sonnei) | کلنیها صاف و در ابتدا بیرنگ هستند و به دلیل تخمیر کند لاکتوز، با انکوباسیون بیشتر صورتی کم رنگ میشوند. |
| گونههای انتروباکتر/کلبسیلا (Enterobacter/Klebsiella spp.) | کلنیهای موکوئیدی (Mucoid) کم رنگ و بزرگ با مرکز صورتی |
موارد استفاده از محیط کشت DCA
- دئوکسیکولات سیترات آگار برای جداسازی و افتراق باسیلهای رودهای گرم منفی در محیط آزمایشگاهی استفاده میشود.
- این آگار به ویژه برای جداسازی ارگانیسمهای عامل اسهال خونی باسیلی، سویههای سالمونلا (که باعث مسمومیت غذایی میشوند) و سالمونلا پاراتیفی (Salmonella Paratyphi) مفید است.
محدودیتهای محیط کشت DCA
- پاتوژنهای مشکوک باید قبل از شناسایی روی محیطی که قابلیت مهار رشد کمتری دارد، کشت شوند.
- از آنجایی که باکتریهای زیادی وجود دارند که در DCA شبیه سالمونلا هستند، اکیدا توصیه میشود که از آگارهای انتخابی بیشتری برای شناسایی سالمونلا استفاده شود، برای مثال: زایلوز لیزین دئوکسی کولات آگار (Xylose Lysine Deoxycholate (XLD) agar).
- این محیط کشت به گرما حساس است و باید در اسرع وقت پس از افزودن دئوکسیکولات در پلیت ریخته و خنک شود، در غیر این صورت، بسیار نرم شده و کار با آن دشوار خواهد شد.
- برای بررسی روتین نمونههای مدفوع و ادرار، پیشنهاد میشود از محیطهای دیگر مانند مککانکی آگار (MacConkey Agar)، بیسموت سولفیت آگار (Bismuth Sulphite Agar) و غیره، همراه با این محیط استفاده شود.
- آزمایشات بیوشیمیایی بیشتری برای شناسایی گونه مورد نیاز است.
- به دلیل نیازهای غذایی مختلف، برخی از ارگانیسمها ممکن است رشد ضعیفی در این محیط از خود نشان دهند.
جهت خرید و یا استعلام قیمت با ما تماس بگیرید یا در واتسپ پیام بزارید
همچنین بخوانید:
- اشدون آگار (Ashdown’s Agar): ترکیب، اصول، آمادهسازی، نتایج و کاربرد
- برد پارکر آگار (Baird Parker Agar): ترکیب، اصول،آمادهسازی، نتایج و کاربرد
- اندو آگار (Endo Agar): ترکیب، اصول، روش آمادهسازی و کاربرد
- مانیتول سالت آگار (محیط کشت MSA): ترکیبات، کاربرد، تهیه
- آگار SCA (نشاسته کازئین آگار): ترکیب، کاربردها، آماده سازی و تفسیر
مترجم: صادق حسینیکیا



